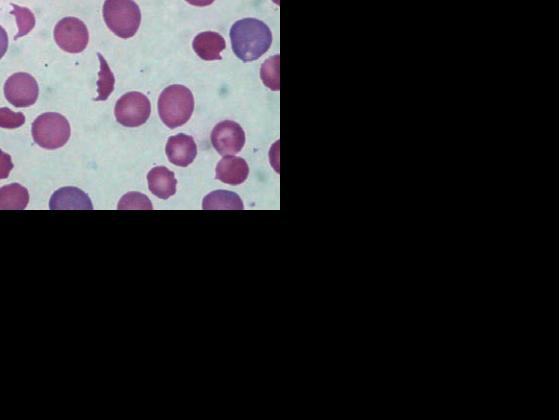

Basic HTML Version

re, sebbene la condizione posta da Newton non
si verifichi mai, la sua legge è la premessa fonda-
mentale per poter studiare i moti dei corpi e le
forze che li producono. Allo stesso modo la legge
di Hardy-Weinberg costituisce un modello che
permette di studiare come le frequenze alleliche si
modifichino, di generazione in generazione, nelle
popolazioni naturali e di individuare le cause di
questi cambiamenti. Se la frequenza degli alleli
A
e
a
nel caso appena analizzato si modificasse nel
corso di alcune generazioni e diventasse
p
= 0,7 e
q
= 0,3, potremmo affermare che il pool genico
della popolazione sta cambiando in una certa di-
rezione (aumento della frequenza dell’allele domi-
nante) e con una certa velocità (che dipende dal
numero di generazioni considerate).
Il verificarsi di cambiamenti nelle frequenze al-
leliche in una popolazione, prova evidente che essa
si sta modificando nel tempo, è detto
microevolu-
zione
.
4
Microevoluzione:
i fattori che modificano
l’equilibrio
In accordo con le idee di Darwin, la teoria sinteti-
ca individua nella selezione naturale la principale
“forza” in grado di modificare i pool genici; data la
sua peculiarità di essa parleremo nel § 5. In que-
sto paragrafo ci occupiamo invece di altri fattori
in grado di produrre un effetto sul pool genico: le
mutazioni
, il
flusso genico
, la
deriva genetica
e gli
accoppiamenti non casuali
. Si tratta di fattori che
non producono necessariamente un adattamento
all’ambiente, anche se a volte possono farlo e avere
quindi
valore adattativo
.
4.1
Le mutazioni: quando si
verificano “errori di copiatura”
Le mutazioni sono cambiamenti ereditari del ge-
notipo, provocati da errori che avvengono durante
i processi di produzione dei gameti. Le mutazioni
possono interessare geni strutturali, che codificano
per specifiche proteine, e geni regolatori, responsabili
dall’attivazione o della disattivazione di altri geni nel
corso dello sviluppo embrionale. Esse rappresentano
l’unico fattore che, provocando la modificazione di
L’equazione di Hardy-Weinberg viene appli-
cata anche in ambiti diversi da quello evolu-
zionistico. Può essere utilizzata per studiare,
nel pool genico di una popolazione, le varia-
zioni nel tempo delle frequenze degli alleli
che causano malattie genetiche. Consideria-
mo il caso della talassemia maior, malattia
recessiva che in Italia ha una frequenza di un
malato ogni 10 000 nati e determina una ridu-
zione e anche alterazioni strutturali dei globu-
li rossi in circolo, e di conseguenza un forte
calo dei valori ematici di emoglobina (
1
).
Possiamo in primo luogo determinare la fre-
quenza q
2
dei malati (omozigoti recessivi aa):
q
2
= 1/10 000 = 0,0001
da questo valore ricaviamo q, ossia la fre-
quenza dell’allele recessivo:
q =
√
0,0001 = 0,01 (1%)
La frequenza dell’allele dominante è:
p = 1 – 0,01 = 0,99 (99%)
Possiamo ora ricavare la frequenza dei porta-
tori sani (eterozigoti) 2pq:
2pq = 2 x 0,001x 0,99 = 0,0198 (1,98%)
Che cosa possiamo dedurre da questo ri-
sultato? Che circa il 2% della popolazione è
portatore dell’allele malfunzionante: un nu-
mero di individui molto più elevato di quello
dei malati. Per questo motivo la quasi totalità
delle persone affette da malattie genetiche
recessive nasce da portatori sani, non dai
malati. Questo fatto renderebbe inutile, al di
là dell’aspetto etico, qualsiasi intervento eu-
genetico di sterilizzazione dei malati.
S
cheda
1
La legge di Hardy-Weinberg e gli studi sulla frequenza delle
malattie genetiche
4
Di che cosa si occupa la genetica di popolazione
e che cos’è un pool genico?
5
Che cosa afferma la legge di Hardy-Weinberg e
in quali casi vale? Con quale formula matemati-
ca può essere espressa?
Facciamo il punto
Figura 1
Globuli
rossi anomali nel
sangue di una
persona affetta da
talassemia.
www.apprendiscienza.it
I fattori che influenzano
la variabilità
Factors
influencing
variation
305-335_sn_v1_B3.indd 309
08/01/

